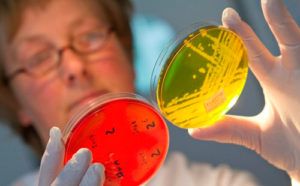

Многие врачи считают проблему паразитов в организме человека недооцененной, и не вполне изученным их воздействие на возникновение некоторых заболеваний. По мнению специалистов, на рост заражения населения паразитами влияет туризм (инвазия происходит через пищу и воду в экзотических странах), миграция – паразитов переносят в развитые страны потоки жителей из стран Африки и Азии.
Массовые поставки зараженной продукции из стран Азии (рыба и морепродукты), нарушения технологии при изготовлении мясных продуктов, производимых неконтролируемыми предприятиями из зараженного сырья, резко повышают угрозу заражения всех слоев населения.

Паразиты, их влияние на организм
В теле человека могут обитать организмы, питающиеся его клетками и предназначенной для него пищей, ничего не давая взамен. Эти существа – паразиты.
Различают более сотни видов этих организмов, которые могут селиться во всех частях человеческого тела – от пищевода до мозга. Различна и их величина – от микроскопических простейших до метровых червей. В организме человека живут два типа гельминтов:
- круглые, или нематоды;
- плоские, которые подразделяются на ленточных червей и сосальщиков.
Анализы на выявление паразитов назначаются для диагностирования при:
- болях и дискомфорте в кишечнике, расстройстве пищеварения, которые проявляются нарушениями стула, метеоризмом, воспалительными заболеваниями;
- различных аллергиях;
- болях в суставах;
- изменениях веса в ту или иную сторону;
- снижении иммунной защиты организма;
- состоянии хронической усталости;
- бруксизме, нарушениях сна, излишней нервозности;
- кожных заболеваниях;
- заболеваниях дыхательных путей.

Массивная инвазия или большие размеры глистов ухудшают работу пищеварительного тракта и желчных протоков, вызывая воспаления печени и запоры, продукты жизнедеятельности гельминтов провоцируют метеоризм и поносы.
Реакция организма на вещества, выделяемые паразитами, приводит к воспалительным заболеваниям и болезненности суставов, повышенной выработке специфических кровяных клеток, которые вызывают аллергию.
На появление паразитов в организме человека указывают разрастания и воспалительные заболевания кожных покровов – сыпь различного рода, бородавки, фурункулы.
Продукты жизнедеятельности, выделяемые глистами в кровь, сильно ослабляют не только иммунную, но и нервную систему человека, провоцируя беспокойство и депрессию, вызывая повышенную утомляемость.
Состояние хронического отравления, постоянного стресса, острая нехватка питательных веществ в организме, которая провоцируется гельминтами – прямой путь к развитию новообразований.
Обычно отравления организма и мощные аллергии вызывают аскариды и трихинеллы, кровотечения и анемии из-за травм внутренних органов провоцируют анкилостомы, закупоривать кишечник и просвет желчных проток могут аскариды, острую нехватку питательных веществ вызывают ленточные глисты. Анализы на паразитов позволяют правильно установить диагноз при анемиях, аллергиях, различных нарушениях веса и назначить адекватное лечение.
Методы определения инвазий
Для подтверждения диагноза о наличии глистов в организме необходимо задействовать весь спектр имеющихся методов лабораторных исследований.

Наиболее точно подтвердить или опровергнуть диагноз могут только:
- присутствие специфических антител в крови;
- яйца глистов в испражнениях или тканях тела;
- обнаруженные части взрослых гельминтов или их личинки во взятых для анализа образцах фекалий или тканей.
Другие применяемые методы лабораторных исследований (рентген, биорезонансное сканирование) не смогут с полной вероятностью подтвердить наличие паразитов в теле больного, но помогут определить места поражения и установить возможность существования паразитов в головном мозге, сетчатке глаз пациента.
Многих интересует, какие анализы нужно сдать больному для подтверждения глистного заражения? Способы, как выявить паразитов в организме делятся на:
- клинические, при которых анализируются биологические жидкости человеческого тела (кровь, кал, моча, желудочный сок), рвотные массы, соскобы с кожи и слизистых, проводится иммунологическое изучение состояние организма;
- биологические, при которых анализируется уже выявленный в организме паразит, цикл его развития и зараженность внутренностей человека;
- морфологические, при которых изучаются образцы тканей, взятых из частей клеток органов, которые подозреваются в инвазии.
Один из общеклинических методов (развернутый анализ кала на паразитов) традиционно применяется при диагностировании глистных инвазий. Но метод не отличается надежностью – если цикл жизнедеятельности глистов не совпадает с периодом исследования и яйца не обнаружены в фекалиях – это нельзя считать подтверждением их отсутствия.
Для более точного изучения проводят несколько циклов исследований, но это не дает гарантии точности и полноты анализа на наличие паразитов в организме человека.
Если есть подозрение на глистную инвазию тканей (цистерцикоз или трихинеллез), проводится биопсия для более полного диагностирования. Серологическое изучение плазмы крови позволит определить локализацию инвазии в теле человека (кишечник, мозг, печень).
Если в фекалиях или рвотных массах есть экземпляр паразита, то биологическое исследование поможет сразу поставить диагноз и установить схему лечения, если фрагментов паразитов недостаточно для определения типа инвазии, проводится многоразовый забор материала и несколько циклов изучения каждые 3–5 дней.
Общеклинические методы
При необходимости подтверждения поражения глистами органов человека врач направляет на целевой анализ для выявления паразитов – диагностику именно тех жидкостей, в которых абсолютно точно обнаружатся их следы (кал при подозрении на кишечных гельминтов, желчь – при печеночных поражениях). Какие анализы сдают для этого?
При предположении на глистную инвазию обычными назначениями будут общеклинические методы исследования и диагностики.
Стандартный анализ кала
Первый метод позволяет выявить инвазии кишечника такими паразитами:
- нематодами – власоглавами, аскаридами, томинксом, кривоголовкой;
- сосальщиками – различными двуустками, шистосомой;
- ленточниками – цепнями и лентецами (малым и широким).
Анализ кала
Для определения яиц глистов, их фрагментов и личинок, цист, простейших используют методы микроскопического исследования. Обычно после обнаружения биологического материала дополнительные способы анализа не применяются.
Анализы на выявление оставшихся паразитов повторяют через месяц после завершения назначенного лечения. Всего проводится три забора кала через 3–4 дня для контроля за появлением яиц. При отрицательном значении третьего анализа крови на паразитов лечение считают эффективным.
Развернутое исследование кала
Такой комплексный анализ позволяет выявить паразитов в организме за счет исключения субъективного фактора при анализе (лаборант не всегда может заметить биологический материал глистов). Для определения инвазии используют метод цепной реакции полимеразы, которая проявляет ДНК паразитирующего в теле человека организма, даже если он погиб или находится в стадии цисты.
Развернутый анализ на паразитов часто позволяет обнаружить их следы у больного, даже если результаты ранее сданных тестов были негативными.
Проведением такого анализа на паразитов по крови можно диагностировать до 17 видов, что позволит назначить правильное и эффективное лечение.
Анализ кала после чистки кишечника
С помощью этого метода можно выявить кишечных паразитов и лямблий.
Для исследования нужно несколько проб, их формируют так: больному дают слабительное, после каждого испражнения отбирается образец, нумеруется, затем на следующий день проводится их анализ. Обычно следы инвазий обнаруживаются не ранее 5–6 образца. Даже если получен отрицательный результат, нельзя с полной уверенностью утверждать, что глистов в организме нет – метод имеет всего 50% эффективность.
Исследование слизи
Метод лабораторного исследования слизи из прямой кишки позволяет определить инвазию лямблиями (которые во многих случаях являются провокаторами синдрома раздраженного кишечника) и некоторыми другими видами паразитов. Для анализа при помощи специального зеркала отбирается мазок слизи, который подвергается микроскопическому исследованию.
Для определения инвазии острицами применяют мазок промежности. Для этого утром забирают соскоб из области ближе к анусу (острицы выползают для откладывания глистов ночью).
Анализы крови
Исследование фекалий иногда не способно выявить инвазию. Более информативен анализ крови – он будет лучшим способом для подтверждения признаков существования паразитов и позволяет диагностировать тканевые инвазии (эхинококк, власоглавы, паразитирующие в тканях, не выделяют яйца в кишечнике и исследование кала не может его обнаружить).
Исследовать кровь на паразитов возможно через выявление антител к определенному виду глистов, что позволит выявить их наличие, глубину поражения организма человека. Как называется анализ крови на паразитов, который позволит определить засевшего в организме вредителя?
Современный метод использует анализ на антитела, которые специфичны для каждого вида и вырабатываются в ответ на токсины, выделяемые гельминтами.
Используемые виды анализа
Для выявления глистной инвазии используют:
ИФА крови
- метод иммуноферментной диагностики (ИФА), основан на поиске и определении специфических белков (иммуноглобулинов) которые синтезируются в теле человека, как ответная реакция на вещества жизнедеятельности паразитов (антигены). ИФА крови на паразитов показывает наличие их в 9 случаев из 10 – это самый эффективный метод. Иммуноферментный анализ покажет паразитирующий биологический вид, уровень поражения организма и его процесс – маркером служит уровень антител. Такой тест крови на наличие паразитов входит составной частью в комплексный анализ наличия гельминтов (исследования жидкостей и выделений организма на яйца и цисты глистов под микроскопом);
- метод иммуноферментной диагностики считается лучшим в связи с возможностью выявить следы инвазии при небольшом количестве паразитов, из паразитирования в тканях;
- метод цепной реакции полимеразы позволяет проанализировать наличие чужеродного ДНК в организме больного, заражение простейшими, но не дает возможности распознать степень инвазии;
- серологические (исследующие плазму крови) исследования для определения антител, использующие реакции – непрямой агглютинации, связывания комплемента, иммунофлуоресценции.
Иммуноферментный анализ (ИФА) на паразитов дает возможность установить факт присутствия:
- простейших (лямблий);
- организмов, поражающих желчные пути, поджелудочную железу и печень;
- ленточных гельминтов всех видов.
В некоторых случаях простое лабораторное исследование крови может косвенно указать на заражение. Повышенный уровень эозинофилов (разновидность лейкоцитов) трактуют как аллергический ответ организма. Во многих случаях это указывает на таких паразитов, как аскариды, нематоды, острицы.
Процедура сдачи анализа
Для максимально объективного результата пациент должен знать как сдать анализы на паразитов.
Ужин должен быть за 8 часов до сдачи крови, если ее сдают утром – больному завтракать нельзя. Прием крепких спиртных напитков, пива и слабоалкогольных миксов прекращают за 48 часов, а сладкой газировки – за 24 часа до сдачи крови. За 2 часа до этого нельзя курить.
Прием медицинских препаратов запрещен на протяжении 3 суток до сдачи крови. Если существуют объективные медицинские показания для лекарственной терапии, перед тем, как сдавать анализ, это следует обговорить с врачом. За 24 часа до процедуры не следует проходить УЗИ или томографии, рентгеноскопию.
Сдавать анализы на паразитов взрослому необходимо из вены на руке, если определяют зараженность новорожденного, кровь берут из пупочной вены.
Исследование покажет (или не выявит) следы паразитарной инвазии, его результат станет основанием для выбора врачом схемы лечения. Повторный забор крови необходим для ИФА при получении неконкретных результатов или как контрольное исследование после проведенной терапии. Между анализами нужно выдержать 14 дней.
Дополнительные методы исследований
После осмотра и сбора анамнеза, врач определит, какой анализ сдать на паразитов. Кроме основных, традиционных исследований, могут применяться:
Дополнительные анализы на паразиты
- изучение откашливаемой мокроты из дыхательных путей для определения паразитов, основной цикл жизни которых проходит в тканях легких и не попадающих в кишечник (нематоды, угрицы кишечные);
- анализ мочи на определение сосальщиков или шистосоматид;
- микроскопическое изучение крови, которую забирают на протяжении 3 суток каждые 6 часов без перерывов (для выявления ночной активности паразитов);
- забор кусочка потенциально пораженной ткани – мышцы на солитера, печени – на «странствующих» глистов, эхинококковых разрастаний – на особый вид ленточного гельминта;
- забор материала из полых органов с помощью вакуумных приборов (для толстой кишки, легких, 12-перстной кишки и прочих органов).
Правильно проведенные исследования помогут врачам определить причину заболевания и не лечить несуществующие болезни.
Паразиты – это микроорганизмы, которые живут и питаются за счет иных организмов. Зачастую паразиты наносят вред организму хозяина. Принято подразделять паразитов на такие виды, как зоопаразиты и фитопаразиты. К зоопаразитам относятся простейшие, гельминты, паукообразные, насекомые и прочие. К фитопаразитам – бактерии, грибы, некоторые высшие растения и другие. Также паразитами являются вирусы. В большинстве случаев для жизни паразитам необходимо сменить два-три хозяина, у которых они вызывают истощение организма и его ослабление. Часто приводят к гибели хозяев. Большая часть паразитов являются возбудителями многих заболеваний человека. В медицинской терминологии к паразитам относят каких-либо существ, которые ведут паразитирующий образ жизни. Исключением являются бактерии, вирусы и грибы.
Диагностика паразитов у человека
Существует ряд заболеваний человека, которые вызываются такими паразитами, как простейшими, паразитическими червями, членистоногими и патогенными микроорганизмами. К простейшим паразитам относят амеб, лейшманий, лямблий, плазмодий, трипаносом, балантид, пневмоцист, токсоплазмий и других. К паразитическим червям – гельминтов. К членистоногим – насекомых и клещей. А к патогенным микроорганизмам – бактерии и спирохеты, которые паразитируют у клещей, блох, вшей, патогенных грибков и вирусов.
Основной целью паразитов считается скрывание своего существования. То есть они живут незамеченными в теле хозяина. Сдача анализа на паразитов предполагает наблюдение их выхода (амеб, члеников, глистов, остриц) или же продуктов размножения паразитов (яиц, цист простейших). Диагностике подвергаются кал, моча, мокрота или ткани организма человека (кровь и лимфатические узлы).
Выделим перечень исследований, которые используются для этого:
- гистологическая копрограмма;
- гистологический анализ по Чернышовой;
- иммунологические (серологические) тесты;
- микроскопирование (гемосканирование);
- электроакупунктурные методы (ВРТ — вегеторезонансное тестирование).
Анализа методу гистологической копрограммы предполагает диагностику тонких срезов образца кала оптическими системами. Он дает возможность четко определять части тел гельминтов, их яиц и оболочек (кутикул) личинок. Таким образом, происходит выявление гельминтоза. Дополнительной возможностью данного метода является определение вида найденных паразитов.
Более эффективным является серологическое исследование крови, при котором происходит выявление антител к гельминтам. Такой метод еще называют иммунологическим (серологическим) тестом. Суть теста заключается в использовании различных наборов химических реагентов и маркеров. Они применяются для установления в крови человека определенных видов антител и антигенов паразитов. Иммунологическое исследование проводится только в медицинских лабораториях.
Анализ по методу микроскопирования основана на применении темнопольных, люминесцентных и электронных микроскопов. Данная диагностика дает возможность изучать живых или фиксированных микроскопических объектов, а также клеточных и субклеточных структур.
Электроакупунктурный метод основан на использовании специальных приборов для выявления основных данных о состоянии здоровья человека. По этому методу исследуются различные участки кожи.
Гистологический анализ по Чернышовой – это обычный метод исследования кала на наличие паразитов различного рода. В большинстве случаев применяется для определения глистных инвазий в биоматериале человека. Может проводиться для взрослых и детей.
Гемосканирование (исследование крови) дает возможность установить состояние основных элементов крови и чистоту ее плазмы. При сдаче анализа на паразитов, который основан на таком методе, кровь не подвергают обработке (то есть не сушат и не окрашивают). Ее исследование проводится при помощи микроскопа, который соединяется с видеокамерой. Далее происходит увеличение образца исследуемого материала под микроскопом в 1800-2000 раз. В этот момент монитор транслирует получаемое изображение, а также при этом предоставляется возможность произвести фотосъемку или видеосъемку. Гемосканирование позволяет получить данные о состоянии иммунной системы и ее активности, а также выявить наличие бактерий, грибков и личинок гельминтов.
ВРТ (вегетативный резонансный тест) основан на феномене биологического резонанса, который образуется между препаратом и организмом человека. Таким препаратом выступают информационные носители частот различных видов паразитов. В 1989 году были обнаружены и зафиксированы все частотные данные разнообразных паразитов, грибков и вирусов. Именно такой вид исследования предоставляет возможность оценить состояние человека в данный момент времени. То есть устанавливать уровень нарушений иммунной системы, а также вирусные и бактериальные нагрузки на организм человека, выводить токсины, снижать реакции организма на различные антигены и аллергены и многое другое.
В лаборатории, где сдается анализ по методу ВРТ, особое внимание уделяется определению уровня эозинофилов. Именно их завышенный показатель свидетельствует о наличии аллергических реакций, которые вызваны паразитарными инвазиями. Эозинофилы – это вид белых кровяных клеток, которые могут обезвреживать токсины бактерий. Они принимают участие в аллергических процессах организма человека, могут окрашиваться кислыми красителями. То есть другими словами эозинофилы являются маркерами паразитарных инвазий при нормальном состоянии иммунитета человека.
Анализ на паразитов — какой лучше
Существует много видов анализов, и какой сдать из них лучше, определяет лечащий врач. Наиболее часто используются анализы крови и кала на выявление паразитов различных видов. Среди исследований крови на паразитов можно выделить такие виды:
- анализ крови на лямблии;
- анализ крови на возбудители описторхоз (установление антител вида IgG);
- анализ крови на возбудители эхинококков;
- анализ крови на возбудители токсокарозов;
- анализ крови на возбудители трихинеллезов;
- анализ крови на возбудители аскаридозов.
Материалом для исследования во всех вышеперечисленных методах является кровь, которая берется из вены.
Материалом исследования для выявления гельминтов служит кал. Потому как в нем наиболее часто и проще их обнаружить.
Кому необходимо сдавать анализ?
Сдача анализа крови на паразитов предлагается таким пациентам, которые жалуются на снижение общего самочувствия. Как известно, существуют сотни семейств, паразитирующих в организме человека. Многие из них вырабатывают токсины, отравляющие кровь. Некоторые снижают количество полезных веществ. И при этом заболевания, которые происходят вследствие жизнедеятельности паразитов, тяжело выявить. Потому как симптоматика имеет схожесть с проявлениями многих заболеваний. Анализ крови дает возможность установить количество антител и специфических иммуноглобулинов в организме человека. Именно они выступают паразитарными маркерами.
Во многих случаях дополнительно проводится диагностика крови методом ПЦР (полимеразная цепная реакция). Это исследование считается эффективным и достоверным. Его основным достоинством выделяют преимущество установления многих видов заболеваний в тот момент, когда остальные диагностики бессильны.
Также рекомендуется сдать анализ крови на паразитов при подготовке к вакцинациям, при беременности и после окончания курса терапии от паразитов. Такой анализ необходимо пройти несколько раз (сразу же после лечения и через один-три месяца).
Паразиты — это микроорганизмы, живущие внутри другого живого организма и высасывающие из него питательные вещества. Они наносят при этом непоправимый вред здоровью хозяина, ведут разрушительную деятельность, нарушают функционирование отдельных органов, ухудшают качество его жизни и приводят к постепенной смерти.
Паразиты — это микроорганизмы, живущие внутри другого живого организма и высасывающие из него питательные вещества.
Паразитарные заболевания у человека вредны и опасны вследствие скрытого характера проявлений микроорганизмов.
Гельминты — черви, которые живут в организме человека и провоцируют заболевание — гельминтоз.
Важное значение при выявлении заражения имеют анализы на паразитов, которые позволяют правильно поставить диагноз.
Обследование — это единственный способ обнаружения червей и назначения своевременного лечения.
Гельминты — черви, которые живут в организме человека и провоцируют заболевание — гельминтоз.
Показания для сдачи анализа
Показаниями для сдачи биоматериала по выявлению глистов может быть наличие таких признаков:
- Изжога.
- Диарея или запор.
- Анемия.
- Тошнота, рвота.
- Болевые ощущения в животе, суставах.
- Высыпания на коже.
- Ослабление иммунитета.
- Потеря веса.
- Зуд в анальном отверстии.
- Ухудшение аппетита.
Микроорганизмы поселяются во внутренних органах, тщательно скрываются, ведут паразитарный образ жизни до тех пор, пока орган не истощится и основательно не будет разрушен.
Паразиты уничтожают стенки кишечника, вызывают заражение крови, нарушают функцию центральной нервной системы. Это приводит к падению защитных сил, уменьшению иммунитета, обострению хронических заболеваний.
Какие анализы сдать взрослому?
Анализы бывают 3 видов:
- Профилактические. Обследование проводится с целью обнаружить паразитов даже при отсутствии симптомов. Процедуру проходят по собственной инициативе или при диспансеризации. Частота исследований — 1 раз в год.
- Барьерные. Проверка осуществляется при приеме ребенка в садик, школу, бассейн, во время медицинских комиссий работников при оформлении медкнижки.
- По назначению врача. При симптомах, указывающих на гельминтоз, специалист направляет пациента на обследование кала на яйца глистов и крови на антитела. Процедура тщательная, часто проводится повторно. Если паразиты выявлены, то рекомендуют обследовать всех членов семьи.
Обследование проводится с целью обнаружить паразитов даже при отсутствии симптомов.
Чем раньше провести исследование организма, тем быстрее начнется лечение, а это является залогом сохранения здоровья.
Периодические проверки на гельминтоз особенно необходимы, если существуют следующие факторы риска:
- наличие в доме домашних животных;
- занятия огородничеством и садоводством;
- использование в питье воды, которая не прошла фильтрацию и очистку;
- употребление продуктов без обработки.
Периодические проверки на гельминтоз особенно необходимы, если в доме есть домашние животные.
Существуют такие виды обследований, которые определяют наличие паразитов:
- Исследование кала на яйца глистов.
- Соскоб.
- Анализ крови на антитела.
Врач при необходимости назначает ПЦР-диагностику, для которой подходит не только кровь, но и сыворотка, плазма, другие биовыделения и жидкости.
Анализ крови
Иммуноферментный анализ крови (ИФА) — самый точный и эффективный метод обнаружения антигенов и антител, которые реагируют на наличие паразитов в организме. С его помощью выявляют кишечные паразитозы, цистицеркозы, личинки аскарид, описторхозы, лейшманиозы кожи и органов.
Иммуноферментный анализ крови (ИФА) — самый точный и эффективный метод обнаружения антигенов и антител, которые реагируют на наличие паразитов в организме.
Недостатками анализа на антитела являются высокая стоимость и возможность обследования только в дорогих лабораториях, таких как «Инвитро», «Гемотест».
Анализ кала
Анализ кала является самым простым методом выявления глистов. Путем исследования фекалий обнаруживают не самих гельминтов, а только их яйца. Достоверность существования паразитов в организме при первой сдаче теста намного ниже, чем при обследовании крови.
Гистологическая копрограмма
Гистологическая копрограмма — это микроскопические лабораторные исследования состава испражнений человека. Обследование необходимо для проверки наличия простейших, личинок глистов, цист и их яиц.
Недостатком метода является невозможность определения вида паразита.
Соскоб
Анализ на энтеробиоз называется соскобом или мазком. Его рекомендуют сдавать и взрослым, и детям. Метод намного эффективнее, чем простой анализ кала. Благодаря ему обнаруживают острицы и прочие гельминты, которые скапливаются в нижней части кишечника. Мазок позволяет выявить и таких паразитов на ранней стадии заражения, как:
- бычий или свиной цепень;
- печеночная двуустка;
- власоглав;
- широкий лентец.
Данный анализ рекомендуют сдавать не реже 1 раза в год.
Анализ на энтеробиоз называется соскобом или мазком. Его рекомендуют сдавать и взрослым, и детям.
Результаты
Правильная расшифровка анализов имеет важное значение, ведь от нее зависит постановка диагноза.
В медицине каждому антигену соответствует свое название — IgA, IgG, IgM. При выявлении заражения развернутый анализ крови делают несколько раз для определения класса A, G или M.
М-класс появляется на 4-5 день и сохраняется 1,5 месяца. IgM указывает на патогенное заражение и стремительное распространение паразитов.
G-класс возникает на 21-24 сутки после инвазии и присутствует в крови долгое время. По методу определяется наличие хронической инфекции.
Правильная расшифровка анализов имеет важное значение, ведь от нее зависит постановка диагноза.
А-класс указывает на паразитарную инвазию и самоочищение от заражения. IgA возникает на 2-3 неделе и исчезает через 3 месяца.
Показатели обследование крови по ИФА готовы на 2-9 день в зависимости от паразитов.
Результаты анализа кала указываются на бланке с пометками «обнаружен» или «не обнаружен». При выявлении яиц глистов они идентифицируются и подсчитываются. В норме тест должен показать отрицательный результат.
Если в тестируемой пробе мало биоматериала для анализа, его сдают повторно. Продолжительность результата — 10 дней. Анализ готовится на протяжении 1-6 дней.
Показатели соскоба могут быть готовы уже на следующий день, но врачи рекомендуют делать его 3 дня подряд для уточнения результатов. Отрицательный тест на энтеробиоз обозначает отсутствие остриц.
Как проверить ребенка на паразитов?
Глисты у детей — распространенное явление. Паразиты попадают в детский организм, доставляют дискомфорт малышам и много неприятных моментов родителям. Дети становятся капризными, плохо спят, ухудшается аппетит.
Главные причины заражения — несоблюдение личной гигиены, несовершенство иммунной и пищеварительной систем.
Глисты у детей — распространенное явление. Паразиты попадают в детский организм, доставляют дискомфорт малышам и много неприятных моментов родителям.
Детям врач назначает анализ кала на яйца глистов и соскоб на энтеробиоз в клинических условиях.
При необходимости сдают общий анализ крови. Низкий уровень гемоглобина, увеличенное количество эозинофилов указывают на гельминтоз.
Врач может выписать направление на ИФА-обследование крови, после чего назначает лечение.
Где сдать анализы?
Для обнаружения гельминтов и прочих паразитов врачи рекомендуют сделать анализы в государственной или частной поликлинике, а также медицинской лаборатории, которая предоставляет услуги по таким исследованиям. В частных клиниках также делают комплексное обследование организма, а результаты получают быстрее и оперативнее.
Недостатком частных клиник является высокая стоимость предоставляемых услуг.
Цена на анализ кала в разных клиниках Москвы и Санкт-Петербурга составляет 110-1150 рублей, соскоб — 80-1000 рублей, обследование крови на антитела к антигенам — 300-940 рублей. При оказании срочных услуг их стоимость возрастает.




